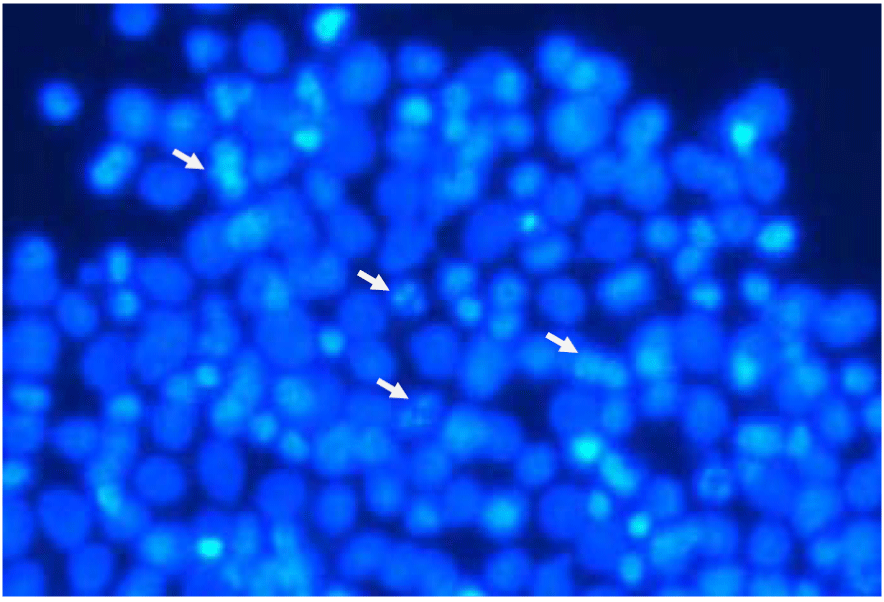

|
| Figure 23: PC3 cells treated with 50ng/ml DR5 captured through fluorescent imaging. Apoptotic cells [bright spots] have been indicated with white arrows. In this case, the PC3 cells were treated with 50ng/ml DR5 and were incubated for 24 hours before being stained. The treatment with 50ng/ml DR5 obtained 50.67% of apoptotic cells. |